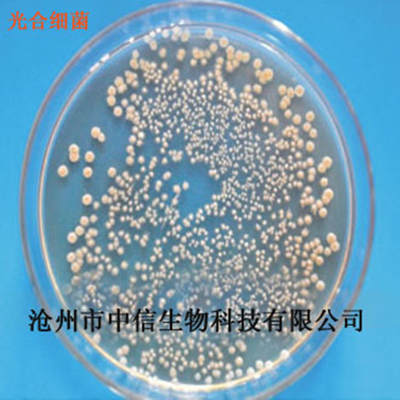

bag bogg

Turnover box filter box fish pond water circulation system fish tank drip box upper filter device Marsh outdoor pool drip
Original Price: $279 Sale Price: $279

Swamp Butcher Off-road Vehicle X029 Cross-border Wholesale Small Particle Building Blocks Toy Army Green Rubber Boat Accessories Beach Sea
Original Price: $20 Sale Price: $20
Photosynthetic bacteria Rhodomonas Marsh regulate water balance pH value supplement nutrition degradation ammonia nitrogen
Original Price: $40 Sale Price: $40

River-crossing marshland pressure stabilizing bag natural gas pipeline balance pressure bag stabilizing pressure block counterweight pressure bag
Original Price: $172 Sale Price: $172

Love and Nancy Thirteen Lines 2024 Winter White Duck down American Casual Thickened Kendou Bread down Jacket Women 40919
Original Price: $732 Sale Price: $732

Huayun pipeline crossing river pressure stabilizing bag crossing river swamp pressure stabilizing bag natural gas pipeline balance pressure bag
Original Price: $152 Sale Price: $152

Medicine EVA sealed bag in stock grain fresh-keeping bag frosted Pill portable storage eva food grade self-sealing bag
Original Price: $24 Sale Price: $24

Turtle Box with Oxygen Circulation Water Purification Accessories Filter Turtle Tank Fish Tank Three-In-One Swamp Fish Tank Filter
Original Price: $14 Sale Price: $14

Finland KEKKILA kaijila swamp charcoal soil 5-40MM without fertilizer (upper basin/for insect eating)
Original Price: $400 Sale Price: $400

Moss artificial plant dried moss turf decoration flower arrangement decorative material
Original Price: $2 Sale Price: $2

EU4344 integrated turnover box European standard auto parts box storage box turtle marsh filter box 40*30*45cm
Original Price: $32 Sale Price: $32

Winter nine-grid lulu new hooded high-end bread simple coat warm 90 velvet goose down super long down jacket
Original Price: $999 Sale Price: $999

Plant moss dried moss water grass lichen DIY flower arrangement decorative materials home decorations fake moss
Original Price: $2 Sale Price: $2

Autumn and Winter Super Popular Retro Niche Suede Women's Bag 2024 New Arrival Light Luxury All-match Crossbody Portable Bucket Bag Trendy
Original Price: $62 Sale Price: $62

Summer yoga pants women's high waist hip nude exercise lu fitness running without embarrassment line does not drop crotch lu thin pants
Original Price: $61 Sale Price: $61

Super Fire Niche Suede Bag Women's 2024 New Autumn and Winter Vintage All-match Crossbody Bag Portable Bucket Bag
Original Price: $62 Sale Price: $62

Ruyi Bird Spray Wool Baby's Baby Cotton Handmade DIY Hand Wool Scarf Line Medium Coarse Blended Material Bag
Original Price: $10 Sale Price: $10

Hanging Ear Triangle Scarf Ice Silk Mesh Breathable Mask cs Military Fan Headgear Riding Windshield Sunscreen Face Scarf Camouflage Scarf
Original Price: $17 Sale Price: $17

Fantasy swamp candy bag party paper flag party horizontal vice flag birthday candy bag
Original Price: $19 Sale Price: $19

Children's Drying Rack Baby's Retractable Drying Rack with Trouser Clip Small Clothes Hanger Clothes Support Baby Hanger Trouser Clip
Original Price: $24 Sale Price: $24

Can be a generation of military camouflage mobile phone waterproof bag hot spring swimming diving compass mobile phone waterproof case
Original Price: $11 Sale Price: $11

50 European and American Cartoon Animation Series Stickers, Cute Graffiti Waterproof Decorative Notebook, Mobile Phone Case, Computer Stickers
Original Price: $7 Sale Price: $7

The new version of the table game Farmhouse owner includes 5-6 people to expand the classic Decze multiplayer entertainment party table game.
Original Price: $26 Sale Price: $26

Package L43 Swamp Butcher Off-road Vehicle Spike Wild Team Men Cross-border Wholesale Children's Assembled Building Blocks Toys
Original Price: $42 Sale Price: $42

in stock wholesale ruyi bird spray yarn 50g medium coarse wool group hand crocheted sweater scarf material bag
Original Price: $9 Sale Price: $9

European and American High Waist Fitness Pants Women's Autumn and Winter fleece-lined Thickened Warm Outer Wearing Yoga Pants Running Sports Leggings
Original Price: $98 Sale Price: $98

Spring and Autumn 2024 New Style Fixed Dye Retro Cloud Texture Soft PU Leather Fabric Short Loose Lapel Jacket
Original Price: $798 Sale Price: $798

Ancient method fish farming water tank ceramic tank retro hydroponic green plant swamp circulation filter notch Chinese inverted vase
Original Price: $56 Sale Price: $56